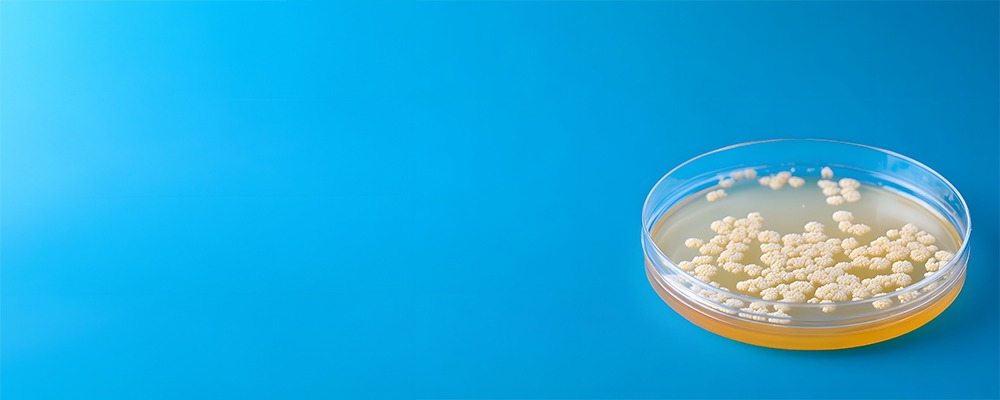

Grains are one of the most important agricultural commodities in the world, serving as the backbone of food, feed, and industrial applications. From baking to brewing and from distilleries to bioethanol production, grain-based processes rely heavily on efficient starch breakdown. Starch is the main carbohydrate in cereals such as maize, wheat, barley, and rice, and unlocking its potential requires a precise and well-tailored enzymatic approach. Choosing the right enzyme is critical, as it directly impacts process efficiency, product quality, and operational costs.
This blog explores the science behind starch breakdown in grains, the types of enzymes available, the factors influencing enzyme choice, and the benefits of selecting the right enzymatic solution for specific applications.
Understanding Grain Starch
Grain starch is composed of two main polysaccharides: amylose and amylopectin. Amylose is a mostly linear chain of glucose molecules, whereas amylopectin is a highly branched structure. These two polymers are packed into granules that vary in size and complexity depending on the type of grain.
For industrial applications, these starches must be broken down into simpler sugars. This is essential for processes such as fermentation, where microorganisms convert sugars into ethanol, or in food production, where starch needs to be transformed into glucose or maltose to enhance flavour, texture, or stability. Efficient hydrolysis of starch requires enzymes that can act on these complex structures with speed, precision, and consistency.
Key Enzymes in Grain Starch Breakdown
Different enzymes play unique roles in the breakdown of grain starch. Selecting the correct combination is crucial for achieving the desired output.
1. Alpha-Amylase
Alpha-amylase is often the first step in starch hydrolysis. It randomly cleaves the internal alpha-1,4-glycosidic bonds in starch molecules, reducing the viscosity of gelatinised starch. This enzyme is particularly valuable in the liquefaction stage of starch processing, where it transforms large insoluble starch molecules into shorter chains called dextrins.
2. Glucoamylase
Glucoamylase works by breaking down dextrins and oligosaccharides into glucose molecules. Its ability to cleave both alpha-1,4 and alpha-1,6 bonds makes it highly effective in producing fermentable sugars. This enzyme is critical in industries such as brewing and bioethanol production, where high glucose yields are required for fermentation.
3. Pullulanase and Isoamylase
These debranching enzymes target the alpha-1,6 linkages in amylopectin, which cannot be broken down by alpha-amylase alone. By removing branch points, pullulanase and isoamylase enhance the action of glucoamylase and improve the overall efficiency of starch hydrolysis.
4. Maltogenic Amylase
This enzyme is designed to release maltose from starch polymers. It is commonly used in the baking industry, where maltose contributes to improved crust colour, flavour, and prolonged softness in bread and other baked products.
Factors to Consider When Choosing the Right Enzyme
Selecting the most suitable enzyme for starch breakdown is not a one-size-fits-all decision. Several factors must be taken into account to ensure maximum efficiency and cost-effectiveness.
1. Type of Grain
Different grains present different starch structures. For example, maize has a higher amylopectin content than wheat, while rice starch granules are smaller and more resistant to enzymatic action. The right enzyme formulation must account for these structural differences to achieve complete hydrolysis.
2. Process Conditions
The pH, temperature, and presence of other chemicals in the process environment significantly affect enzyme performance. Alpha-amylases, for instance, are often thermostable and suitable for high-temperature liquefaction, while glucoamylases generally perform better at moderate temperatures and slightly acidic pH. Matching the enzyme profile with process conditions ensures reliable and repeatable outcomes.
3. Desired End-Product
Whether the goal is to produce glucose for fermentation, maltose for baking, or syrups for sweetening, the enzyme selection varies. For high glucose yields, a combination of alpha-amylase and glucoamylase is ideal. For maltose-rich syrups, maltogenic amylase is preferred.
4. Cost and Efficiency
Enzyme choice directly affects operational costs. A highly efficient enzyme may reduce the dosage required, lower energy consumption, and shorten processing time. Although initial costs may appear higher, the overall savings in productivity and yield make it a more economical option.
5. Compatibility with Other Ingredients
In multi-step processes such as brewing or bioethanol production, enzymes must work seamlessly with yeast or other microorganisms. The choice of enzyme should support not only starch breakdown but also the broader biological and chemical processes that follow.
Applications Across Industries

1. Brewing and Distilling
In brewing, enzymes break down starch into fermentable sugars that yeast converts into alcohol. The balance of maltose and glucose determines both flavour and alcohol content. In distilleries, high glucoamylase activity ensures maximum ethanol yield.
2. Bioethanol Production
The demand for renewable fuels makes starch-based bioethanol production a major industry. Alpha-amylases and glucoamylases are key enzymes that enable cost-effective and sustainable conversion of grain starch into ethanol.
3. Baking and Flour Mills
Enzymes not only break down starch but also influence dough handling, crumb softness, and shelf life. Amylases are vital in enhancing fermentation, crust browning, and flavour development in bread and other baked goods.
4.Food and Beverage Processing
From syrups to juices, starch-degrading enzymes are essential for creating products with consistent sweetness, improved clarity, and better mouthfeel.
5. Pharmaceuticals and Nutraceuticals
In specialised applications, enzymatic starch breakdown is used to produce excipients, active ingredients, and health supplements. The precision of enzymatic action ensures safety and purity in these sensitive industries.
The Future of Starch Breakdown Enzymes
As industries focus on efficiency, sustainability, and innovation, enzymes are evolving to meet new demands. Advances in biotechnology are leading to enzymes with improved stability, broader pH and temperature tolerance, and enhanced specificity. Genetic engineering and immobilisation techniques are also helping to reduce enzyme costs and make industrial processes more sustainable.
Another growing trend is the move towards eco-friendly production, where enzymes are replacing harsh chemicals. This shift not only benefits the environment but also creates safer working conditions and cleaner products for consumers.
Conclusion
The efficient breakdown of grain starch is a vital step across multiple industries, from food and beverages to renewable energy and pharmaceuticals. The right enzyme solution depends on factors such as the type of grain, process environment, end-product requirements, and cost considerations. A thoughtful choice ensures higher yields, reduced operational costs, and improved product quality. By combining scientific knowledge with practical application, industries can achieve consistency, sustainability, and competitiveness in today’s market.
Biolaxi Enzymes Pvt Ltd has been at the forefront of delivering reliable enzyme solutions tailored to the needs of industries worldwide. With over a decade of expertise, a strong focus on innovation, and a commitment to eco-friendly formulations, Biolaxi provides high-quality enzyme products that drive efficiency in starch breakdown and beyond. For businesses seeking dependable partners in enzyme technology, Biolaxi offers the right balance of scientific precision and practical application to help them achieve excellence.
